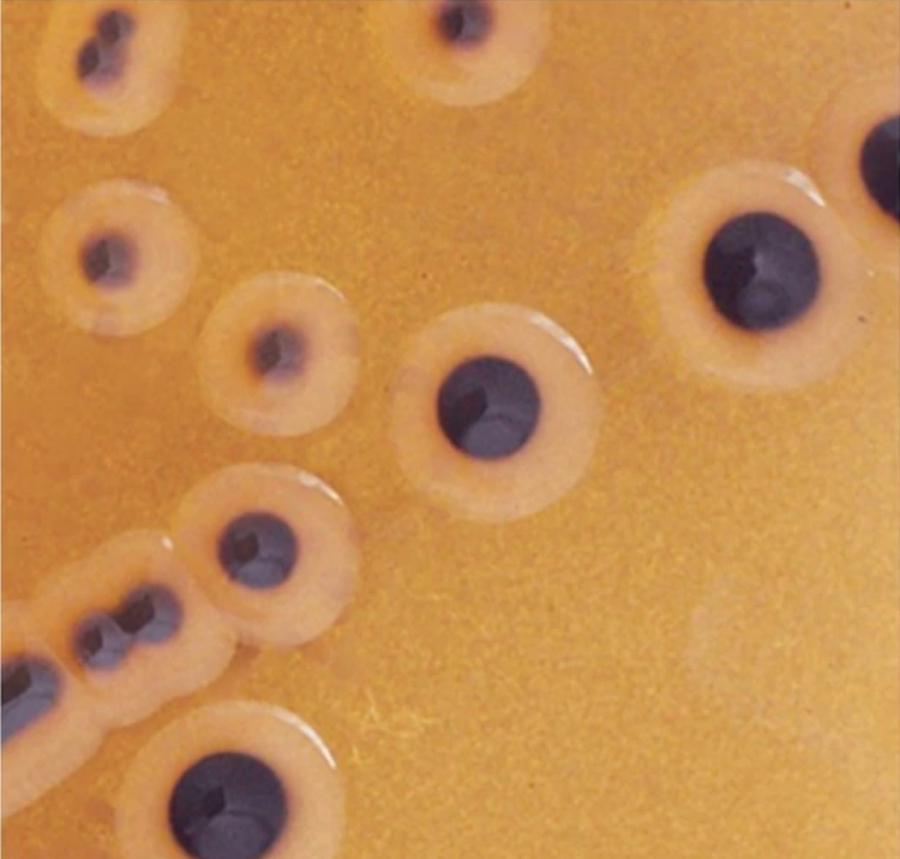

Контрольные штаммы Culti-Loops – одноразовые петли с нанесенным стабилизированным микроорганизмом. Обзор
13.01.2022
Контрольные штаммы Сulti-Loops получены из оригинальных культур коллекции культур ATCC/NCTC (Национальная коллекция типовых культур (бактерий).
Контрольные штаммы Culti-Loops – это:
- каждая партия контрольных штаммов проходит проверку на чистоту, жизнеспособность и биохимические показатели;
- стандартизованные;
- индивидуально упакованы (5 петель в упаковке); одной петлей можно засеять до 5 чашек Петри;
- готовые к использованию, подготовка не требуется;
- простая процедура использования, нет необходимости в использовании игл или пинцетов;
- хранение при 2-8 °C (-18 °C для вида Campylobacter spp.).
Контрольные штаммы Culti-Loops используют для:
- проверки качества питательных сред, диагностических реагентов и т.д.;
- оценки бактериологических процедур;
- поддержания (сохранения) запасных культур.
Методика использования Culti-Loops
Прямой метод с использованием агара (для неприхотливых бактерий):
- предварительно нагрейте среду до 37 °C;
- проведите петлей Culti-Loops по поверхности среды, чтобы она увлажнилась;
- нанесите культуру микроорганизмов в виде полос – одна петля Culti-Loops может инокулировать до 5 чашек Петри;
- инкубируйте при соответствующих параметрах.
Непрямой метод с использованием бульона (для прихотливых микроорганизмов):
- отрежьте ручку петли и поместите петлю в питательный бульон для растворения пленки на петле и встряхните;
- инокулируйте среду несколькими каплями бульона;
- нанесите культуру микроорганизмов в виде полос и инкубируйте при соответствующих параметрах.
Информация для заказа:
Пока нет данных. Перейти в каталог
|
R4605220
|
|
|
По запросу По запросу |
|
|
||||||
|
Контрольные штаммы Сulti-Loops получены из оригинальных культур коллекции культур ATCC/NCTC (Национальная коллекция типовых культур (бактерий).
Контрольные штаммы Culti-Loop используют для:
Методика использования. Прямой метод с использованием агара (для неприхотливых бактерий):
Непрямой метод с использованием бульона (для прихотливых микроорганизмов):
|
|||||||||||
|
R4601232
|
|
|
По запросу По запросу |
|
|
||||||
|
Контрольные штаммы Сulti-Loops получены из оригинальных культур коллекции культур ATCC/NCTC (Национальная коллекция типовых культур (бактерий).
Контрольные штаммы Culti-Loop используют для:
Методика использования. Прямой метод с использованием агара (для неприхотливых бактерий):
Непрямой метод с использованием бульона (для прихотливых микроорганизмов):
|
|||||||||||
|
R4609255
|
|
|
По запросу По запросу |
|
|
||||||
|
Контрольные штаммы Сulti-Loops получены из оригинальных культур коллекции культур ATCC/NCTC (Национальная коллекция типовых культур (бактерий).
Контрольные штаммы Culti-Loop используют для:
Методика использования. Прямой метод с использованием агара (для неприхотливых бактерий):
Непрямой метод с использованием бульона (для прихотливых микроорганизмов):
|
|||||||||||
|
|
|||||||||||
Ниже вы можете задать вопрос или оставить запрос в свободной форме
Вход в личный кабинет
Оформление заказа без регистрации
Для продолжения регистрации введите ИНН
Восстановление пароля
Ссылка для восстановления пароля будет отправлена на Ваш адрес электронной почты
Регистрация пользователя
Заполните, пожалуйста, форму регистрации
Все поля со звездочкой (*) обязательны для заполнения
Все поля со звездочкой (*) обязательны для заполнения
Техподдержка пользователей
Для более быстрого оформления запроса выберите тему обращения
Отмена регистрации
Вы уверены, что хотите отменить создание учетной записи и удалить все данные?
Данное действие необратимо.
Данное действие необратимо.
Да, удалить
Нет, оставить
Зарегистрируйтесь на dia-m.ru,
чтобы сделать работу на сайте еще удобнее!
чтобы сделать работу на сайте еще удобнее!
С помощью личного кабинета Вы сможете:
- моментально получать счета на оформленные заказы;
- отслеживать статусы выполнения заказа по оплате, отгрузке, наличию товаров на складе;
- вести историю заказов, повторять заказы полностью или частично;
- выбирать персонального менеджера;
- формировать списки избранного среди товаров, справочных материалов и видео;
- делать заказ со страницы избранных товаров;
- экономить время при заполнении форм заказа по каталогам и регистрации на мероприятия.